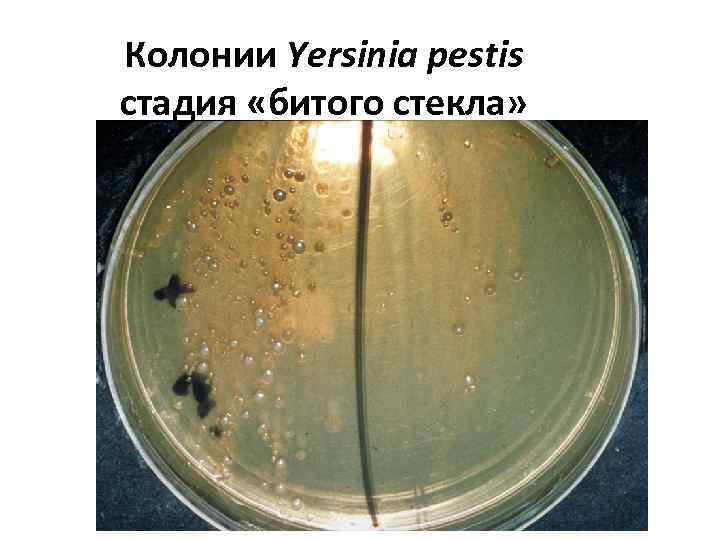
Колонии Yersinia pestis стадия «битого стекла»
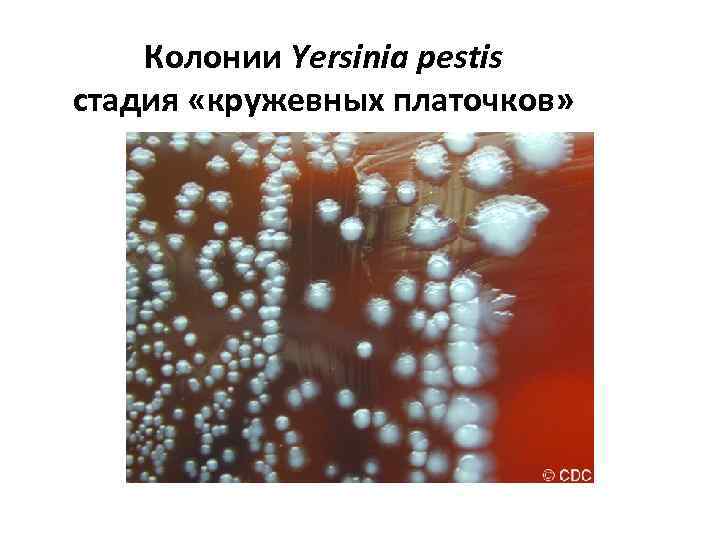
Колонии Yersinia pestis стадия «кружевных платочков»
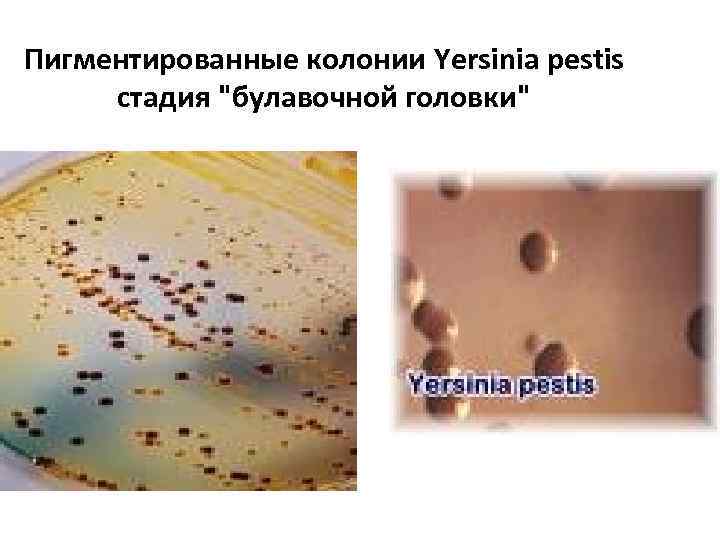
Пигментированные колонии Yersinia pestis стадия "булавочной головки"
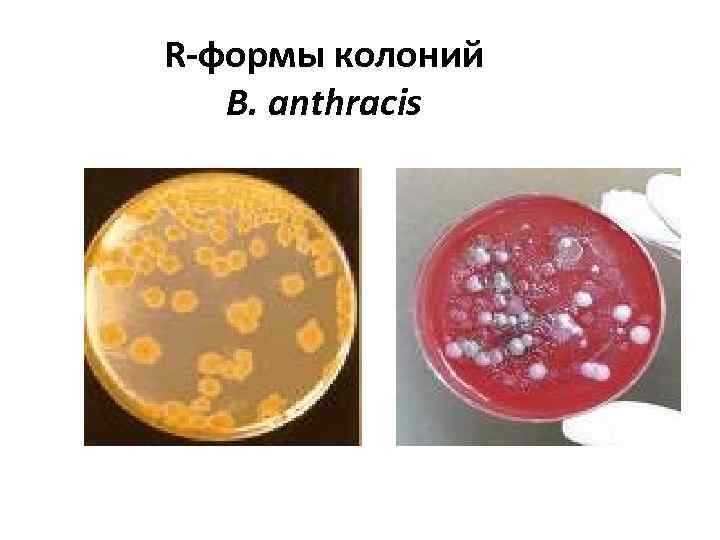
R-формы колоний B. anthracis

6 лекц ООИ 2014.ppt
- Количество слайдов: 68

Возбудители особо опасных зоонозных инфекций (ООИ) СПб. ГУ 2014

План лекции • 1. Возбудители зоонозных инфекций • 2. Чума природно-очаговое заболевание. Резервуары. Пути передачи. • 3. Клинические формы и клинические проявления чумы • 4. Таксономия р. Yersinia • 5. Возбудитель чумы - Yersinia pestis, морфологические свойства • 6. Культуральные свойства • 7. Антигенные комплексы • 8. Факторы патогенности • 9. Лабораторная диагностика • 10. Чувствительность к АМП

1 вопрос Возбудители зоонозных инфекций • Чума – Yersinia pestis • Сибирская язва – Bacillus anthracis • Туляремия – Francisella tularensis • Бруцеллез – p. Brucella Особо опасные инфекции (ООИ)

Бактериолог – работник противочумной станции

Зоонозные инфекции Заражение человека • при контакте с больными животными, • при употреблении зараженных продуктов, • при укусе кровососущих насекомых: блох, вшей, клещей, комаров. • некоторые зоонозные (зооантропонозные) инфекции могут передаваться от человека к человеку.

Yersinia pestis – возбудитель чумы Чума – особо опасное природноочаговое инфекционное высококонтагиозное заболевание, характеризующееся тяжелой интоксикацией, поражением лимфатической системы, септицемией и септокопиемией

Клинические проявления при бубонной чуме

Эпидемии чумы приводили к опустошению целых городов и стран 1348 -1351 – в Европе погибло 24 млн. человек

2 вопрос Чума природно-очаговое заболевание существуют эндемические очаги чумы

Новые независимые государства Азербайджан Армения Грузия Казахстан Киргизстан Россия Таджикистан Туркменистан Узбекистан Украина Площадь, км 2 37 850 23 150 8 000 1 007 350 32 000 253 590 700 416 000 500 0

Резервуары Yersinia pestis • Природный: • Грызуны: суслики, сурки, тушканчики, песчанки • В городах: мыши, черные крысы • Восприимчивы: верблюды, ежи, лисы, кошки, белые мыши, морские свинки, кролики, обезьяны

Пути передачи чумы • • 1. Контактный 2. Трансмиссивный 3. Алиментарный 4. Аспирационный

Пути передачи инфекции

Азиатская крысиная блоха Xenopsylla cheopis передает чумную палочку от крыс к человеку

3 вопрос Клинические формы чумы: основные • Бубонная • Легочная дополнительные • Кишечная • Септическая

Бубонная форма чумы

Бубонная форма чумы паховый бубон

Вскрытый бубон

Геморрагическое воспаление внутренних органов

Легочная форма чумы

Септическая форма чумы с поражением конечностей

Клинические проявления чумы Общие черты • Инкубационный период – 2 -3 сут. • Начало заболевания внезапное – озноб, повышение температуры, головная боль, рвота • Отсутствие язв на месте укуса блохи (в отличие от язвенно-бубонной формы туляремии)

Особые клинические проявления • Бубонная форма чумы • Воспаление регионарных лимфатических узлов, снижение АД, затемнение сознания, бред, "меловой язык" • Патогенез • В бубонах – геморрагическое воспаление, некроз, нагноение, свищ, возможно образование вторичных бубонов

Особые клинические проявления • Легочная форма чумы • Боли в грудной клетке (плевропневмония), кашель, выделение кровяной мокроты • Патогенез • Множественные некротические очаги в легких и очаги геморрагической пневмонии

Особые клинические проявления Кишечная форма чумы • слизисто-кровяная диарея Патогенез • множественные некротические и геморрагические очаги в кишечнике

4 вопрос Таксономия рода Yersinia (11 видов) сем. Enterobacteriaceae • Наиболее патогенные • Yersinia pestis – типовой вид • Y. enterocolitica – возбудитель кишечного иерсиниоза • Y. pseudotuberculosis – псевдотуберкулез или скарлатиноподобная лихорадка

5 вопрос Возбудитель чумы - Yersinia pestis Морфологические свойства • Гр- палочки, длина – 1, 5 -2 мкм, ширина -0, 5 -0, 7 мкм, жгутиков нет, спор не образуют, капсула образуется при 37°С

Клетки Yersinia pestis (сканирующая электронная микроскопия)

Особые тинкториальные свойства • Биполярность при окраске метиленовым синим

6 вопрос Культуральные свойства Yersinia pestis Факультативные анаэробы оpt р. Н – 6, 8 -6, 9 оpt T°С = 28°С психрофилы Чувствительны к высоким Tº Гибнет при 100 о. С – 1 мин. , 80 о. С – 5 мин. , 50 о. С – 40 мин В трупах летом сохраняет жизнеспособность 1 неделю, на холоде – год • Устойчивы к высыханию, при лиофилизации сохраняются годами • Чувствительны к солнечному свету – гибель через • 2 -3 час • •

Рост на ППС • • • Среда Мартена на ППС – характерный рост: 10 -12 час - стадия "битого стекла" 18 час – стадия "кружевных платочков" 24 час – "булавочная головка"
Колонии Yersinia pestis стадия «битого стекла»
Колонии Yersinia pestis стадия «кружевных платочков»
Пигментированные колонии Yersinia pestis стадия "булавочной головки"

Биохимические свойства Yersinia pestis • На основании биохимических свойств и с учетом места обитания разделены на расы (варианты): • крысиная, • сурчиная, • сусликовая, • полевковая, • песчанковая

7 вопрос Антигенные комплексы Y. pestis • I ПОВЕРХНОСТНАЯ ФРАКЦИЯ: FI - капсульная FIa – белок и полисахарид FIb – чистый белок • II ПОВЕРХНОСТНАЯ ФРАКЦИЯ: (белково-липидные комплексы) V- цитоплазматическая мембрана W –наружная мембрана

8 вопрос Факторы патогенности Y. pestis • 1. ПИЛИ • 2. ФЕРМЕНТЫ: нейраминидаза, фибринолизин, плазмокоагулаза • 3. Эндотоксин • 4. Эндогенные пурины • 5. БАКТЕРИОЦИНЫ - ПЕСТИЦИНЫ

Контроль патогенности • • Плазмиды p. YP – плазмида патогенности p. YT – плазмида токсигенности p. YV – плазмида вирулентности

9 вопрос Лабораторная диагностика (только на противочумных станциях) 1. Бактериоскопия 1. Окраска по Граму 2. Окраска метиленовым синим (биполярность) 3. Агглютинация сывороткой (люминесцентный микроскоп)

2. Высев на специальные среды (среда Мартена) при 28 о. С Через 18 часов - стадия « кружевных платочков» 3. Биопробы

10 вопрос Чувствительность к АМП • • тетрациклин левомицетин рифампицин все дезинфицирующие средства • иммунитет различной длительности, возможны повторные заболевания

Bacillus anthracis - возбудитель сибирской язвы • • • 1. Возбудитель сибирской язвы - Bacillus anthracis 2. Клиническая картина заболевания 3. Эпидемиология 4. Таксономия р. Bacillus. Общие свойства представителей рода Bacillus 5. Морфологические свойства Bacillus anthracis 6. Культуральные свойства. Условия образования капсул и спор. 7. Патогенез сибирской язвы. Факторы патогенности B. anthracis 8. АГ структура. Аллергическая реакция на клетки B. anthracis 9. Лабораторная диагностика 10. Профилактика. Чувствительность к АМП

1 вопрос Bacillus anthracis – возбудитель сибирской язвы Сибирская язва (антракс) зоонозное инфекционное заболевание, характеризующееся тяжелой интоксикацией, поражением кожи и лимфатической системы

2 вопрос Клиническая картина заболевания • • • Кожная форма – 90% Легочная Кишечная Сепсис при иммунодефиците Бактериемия при любой форме

Клиническая картина заболевания сибирской язвы (антракса)

Антракс – углевик, карбункул гнойно-воспалительный очаг на коже, в центре которого находится черный струп, похожий на уголь

3 вопрос Эпидемиология • Источник заболевания у животных: • Дикие и домашние животные: овцы, коровы, лошади, свиньи • Заражение через воду и корм • Висцеральные формы заболевания • Источник заболевания у человека: • Заражение через шерсть, кожу животных • Проф. заболевания - кожные

4 вопрос Таксономия р. Bacillus 20 видов • Bacillus anthracis - описан Р. Кохом • B. megaterium • B. subtilis • B. cereus

Общие свойства представителей рода Bacillus • • • ГР+крупные палочки Некоторые подвижны Образуют эндоспоры Каталаза+ Чаще строгие аэробы (некоторые факультативные анаэробы) Для внутривидовой дифференциации используют тесты: Подвижность Ферментативная активность АГ-структура Проверка на биопробах – патогенен только B. anthracis

5 вопрос Морфологические свойства Bacillus anthracis • • • ГР+палочки Ширина 0, 6 -0, 8 мкм, длина 5 -8 мкм Эндоспоры Вне макроорганизма образует цепочки Неподвижны!!! 3 морфологические формы: 1. вегетативная бескапсульная 2. вегетативная капсульная – полипептид!!! 3. споровая

Морфология Bacillus anthracis бескапсульные споровые

Условия образования капсул и спор • Капсула – полипептид! • Капсула образуется только в макроорганизме • Споры образуются вне организма - в почве или при длительном культивировании, при доступе кислорода, при оpt. t° -30 -35°C

6 вопрос Культуральные свойства Bacillus anthracis • • Неприхотливы к составу питательных сред - МПА t° - 12 -43°C оpt. t° - 37°C в аэробных условиях Через 18 -24 ч – на ППС образуют колонии Характерная морфология колоний "Голова медузы" "Львиная грива" Вирулентные в R-форме!!!
R-формы колоний B. anthracis

Дифференциальные среды для антракоидовдвойников (сапрофиты B. сereus дают гемолиз) Bacillus cereus Зона гемолиза Bacillus anthracis

Устойчивость B. аnthracis в окружающей среде • • Вегетативные клетки неустойчивы Споровые формы гибнут при кипячении 1 час В 70° спирте споры сохраняют жизнеспособность 2 -3 часа

Биохимические свойства B. anthracis • Аэробы: • Активно используют сахара с образованием кислоты без газа • Пептонизируют молоко • Каталаза+ • Нитратредуктаза+

7 вопрос Патогенез сибирской язвы • Инкубационный период – от нескольких часов до нескольких суток • Инфекционный процесс – с момента попадания B. anthracis в ток крови • Распространение по лимфосистеме • Размножение в лимфоузлах

Факторы патогенности B. anthracis • • Экзотоксин: ЗА- защитный (протективный) антиген ОФ – отечный фактор ЛФ – летальный фактор Синергидное действие !!!

Компоненты и принцип действия экзотоксина B. anthracis отечный фактор протективный антиген летальный фактор

Схема воздействия экзотоксина

8 вопрос АГ структура B. anthracis • О-АГ- соматический полисахаридной природы – реакция Асколи (термопреципетации) • К-АГ- белковой природы (РИФ)

Аллергическая реакция на B. anthracis • Аллерген B. anthracis - АНТРАКСИН (комплекс Б, ПС, НК) • • Разработана ретроспективная диагностика 1 неделя -90% положительных реакций 15 лет -83% положительных реакций 30 лет – 70% положительных реакций

Иммунитет при антраксе • B. anthracis иммуногенен, но • АТ-образование слабое, сохраняется недолго • Серологические методы не разработаны

9 вопрос Лабораторная диагностика 1. РИФ на определение капсулы 2. Тест с пенициллином (0, 05 -0, 5 мг/мл) «жемчужное ожерелье»

3. Тест на лизис бактериофагами 4. Биопробы

10 вопрос Профилактика • Комплекс санитарно-ветеринарных мероприятий • Специфическая – живая споровая бескапсульная вакцина СТИ • Авторы Гинзбург и Тамарин

Чувствительность к АМП Bacillus anthracis чувствительны к: • стрептомицину • пенициллину ( «жемчужное ожерелье» ) • эритромицину • тетрациклину
6 лекц ООИ 2014.ppt